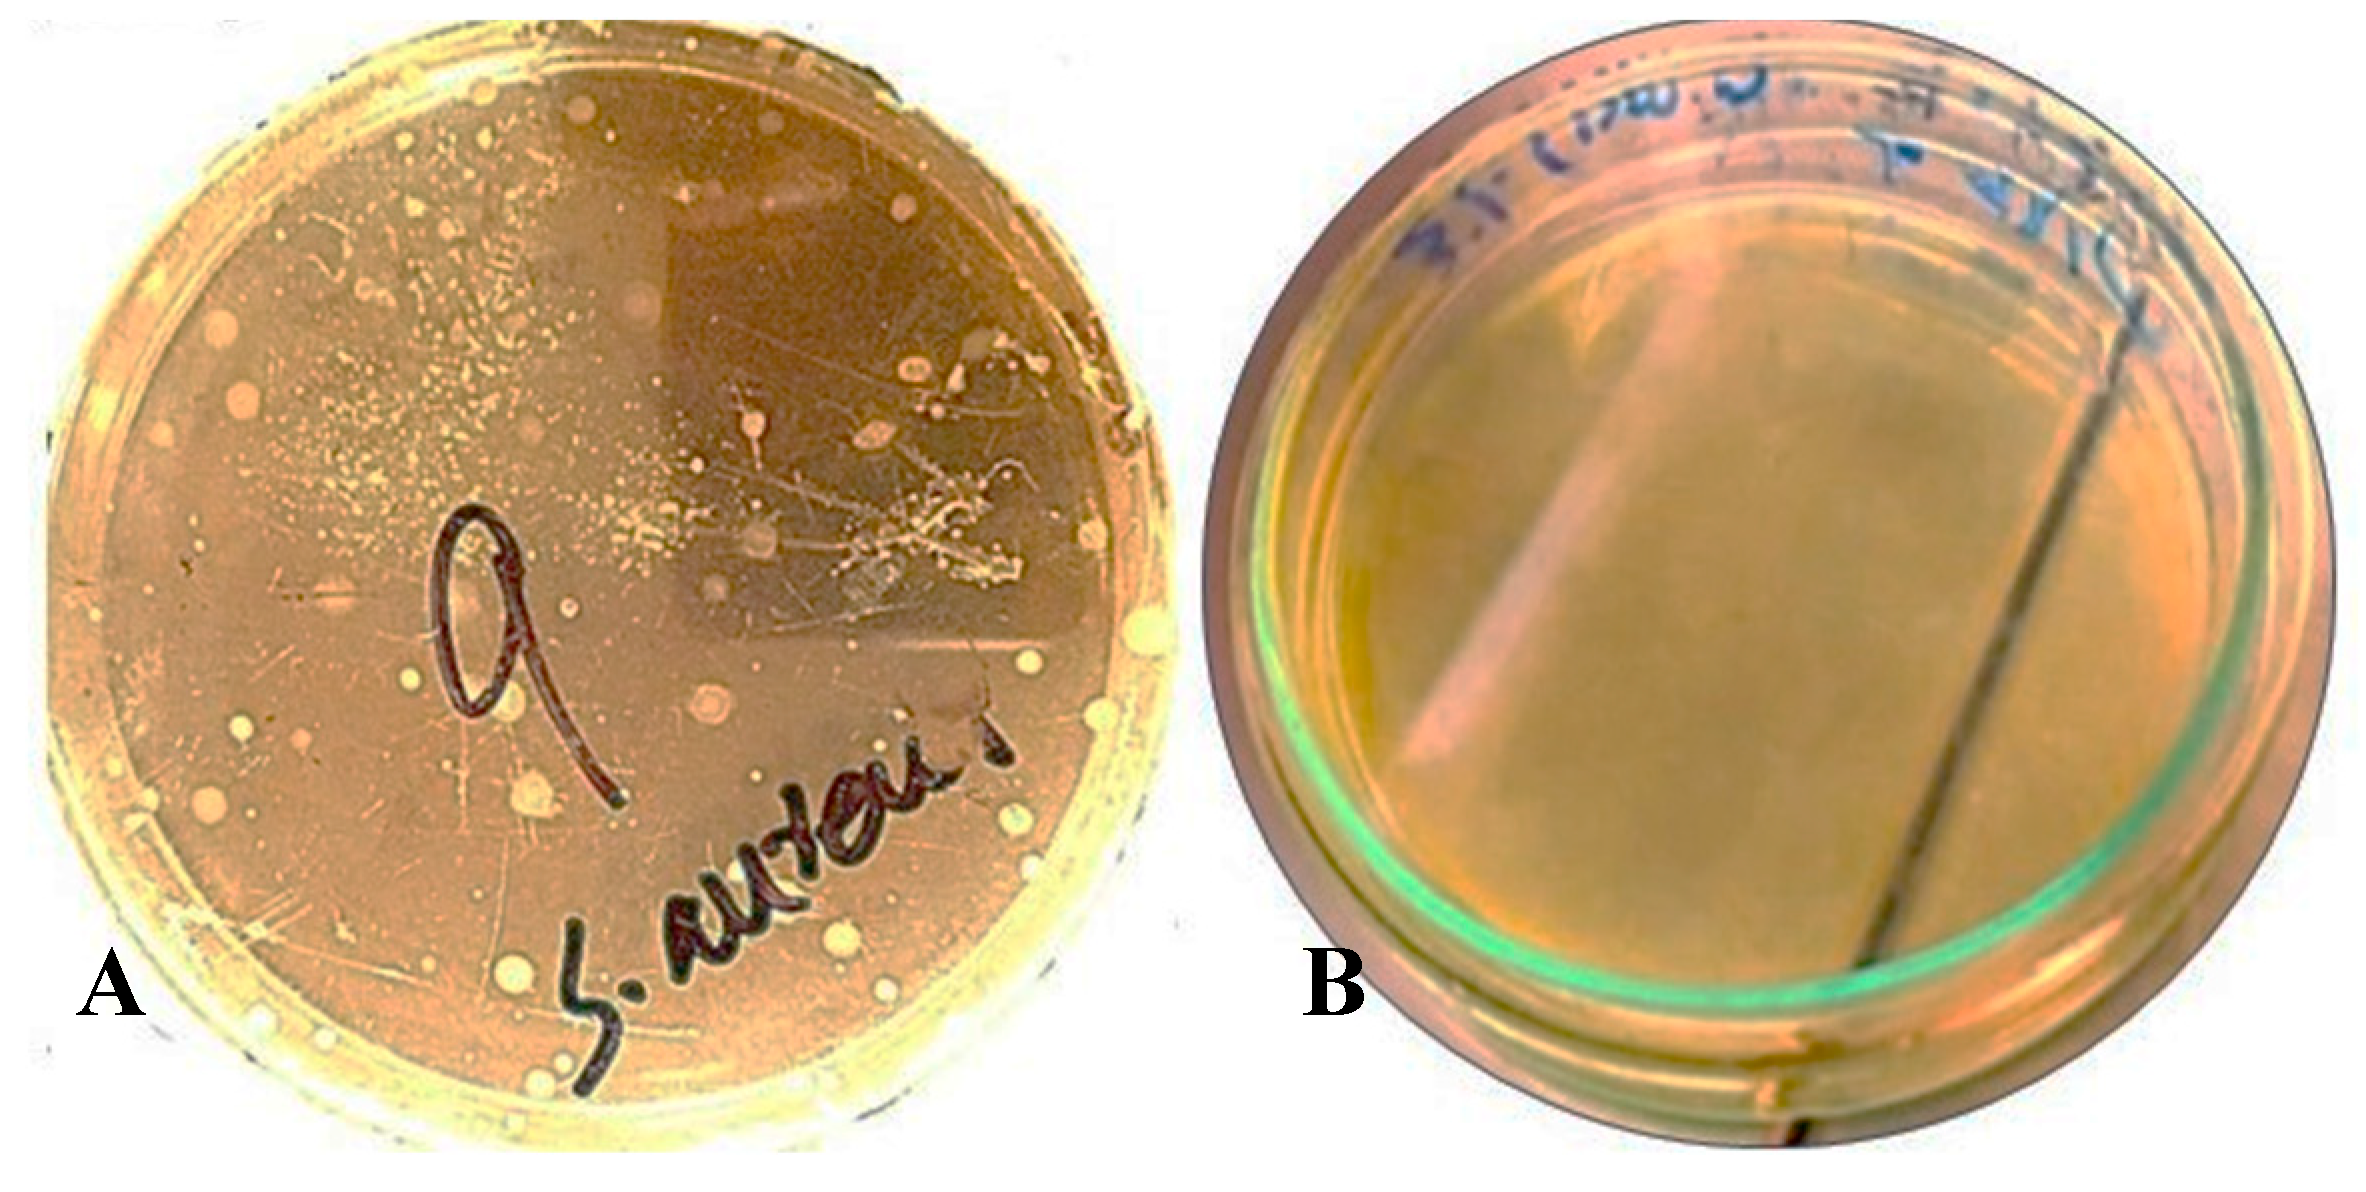
Biology 14 00400 g006

Neem Oil (Azadirachta indica L.) Response Surface Methodology (RSM)-Optimized Nanoemulsions for Sensory Quality Preservation of Oreochromis niloticus Fillets
Simple Summary
Abstract
1. Introduction
2. Materials and Methods
2.1. Chemicals
2.2. Preparation of Nanoemulsions
2.3. RSM for Optimized NE NEs
2.4. Transmission Electron Microscopy (TEM)
2.5. Gas Chromatography–Mass Spectrometry (GC/MS) Analysis
2.6. Determination of Minimum Inhibitory Concentration (MIC) Against S. aureus
2.7. Time–Kill Dynamics
2.8. Protein and Nucleic Acid Leakage
2.9. Surface Preparation
2.10. Preparation of Dip-Coating
2.11. Application of Dipping
2.12. Proximate Analysis of the Dipped Fillets
2.12.1. Moisture
2.12.2. Ash
2.12.3. pH
2.12.4. Protein
2.12.5. Carbohydrates
2.13. Total Plate Count (TPC) of the Fillets
2.14. Sensory Analysis
2.15. Statistical Analysis
3. Results
3.1. Multiple Factor Experiments
3.2. Antibacterial Activity of NO NE and PM (Potassium Metabisulphite) Against S. aureus
3.3. Time–Kills Dynamics
3.4. Protein and DNA Leakage
3.5. Proximate Analysis
3.6. Total Plate Count (TPC)
3.7. Sensory Evaluation
4. Discussion
5. Conclusions
Author Contributions
Funding
Institutional Review Board Statement
Informed Consent Statement
Data Availability Statement
Conflicts of Interest
References
- Badoni, P.; Nazir, I.; Aier, M.; Maity, P.B.; Samanta, S.; Das, A. Significant Role of Fish Nutrients with Special Emphasis to Essential Fatty Acid in Human Nutrition. Int. J. Curr. Microbiol. Appl. Sci. 2021, 10, 2034–2046. [Google Scholar]
- Mishra, S.P.; Pradesh, U. Significance of Fish Nutrients for Human Health. Int. J. Fish. Aquat. Res. 2020, 5, 47–49. [Google Scholar]
- El-Sayed, A.M.; Fitzsimmons, K. From Africa to the World—The Journey of Nile Tilapia. Rev. Aquac. 2023, 15, 6–21. [Google Scholar] [CrossRef]
- Youssef, A.M.; El-Sayed, H.S.; Islam, E.-N.; El-Sayed, S.M. Preparation and Characterization of Novel Bionanocomposites Based on Garlic Extract for Preserving Fresh Nile Tilapia Fish Fillets. RSC Adv. 2021, 11, 22571–22584. [Google Scholar] [CrossRef]
- Sheng, L.; Wang, L. The Microbial Safety of Fish and Fish Products: Recent Advances in Understanding Its Significance, Contamination Sources, and Control Strategies. Comp. Rev. Food Sci. Food Safe 2021, 20, 738–786. [Google Scholar] [CrossRef]
- Salama, Y.; Chennaoui, M. Microbial Spoilage Organisms in Seafood Products: Pathogens and Quality Control. Eur. J. Microbiol. Infect Dis. 2024, 1, 66–89. [Google Scholar] [CrossRef]
- Zhai, X.; Sun, Y.; Cen, S.; Wang, X.; Zhang, J.; Yang, Z.; Li, Y.; Wang, X.; Zhou, C.; Arslan, M. Anthocyanins-Encapsulated 3D-Printable Bigels: A Colorimetric and Leaching-Resistant Volatile Amines Sensor for Intelligent Food Packaging. Food Hydrocoll. 2022, 133, 107989. [Google Scholar] [CrossRef]
- Yang, Z.; Chu, Y.; Zhang, C.; Yan, J.; Xie, J. Changes in the Physicochemical Properties of Grouper (Epinephelus coioides) Fillets Stored under Vacuum Packaging at Chilly Temperature Contributing with the Spoilage Bacteria. Food Biosci. 2023, 55, 103017. [Google Scholar] [CrossRef]
- Zhang, J.; Huang, X.; Zhang, J.; Liu, L.; Shi, J.; Muhammad, A.; Zhai, X.; Zou, X.; Xiao, J.; Li, Z. Development of Nanofiber Indicator with High Sensitivity for Pork Preservation and Freshness Monitoring. Food Chem. 2022, 381, 132224. [Google Scholar] [CrossRef]
- Sharma, H.; Rajput, R. The Science of Food Preservation: A Comprehensive Review of Synthetic Preservatives. J. Curr. Res. Food Sci. 2023, 4, 25–29. [Google Scholar]
- Yewande, O.A.; Esther, F.A.; Ajadi, B.M.; Olowe, A.O. A Review of the Evaluation and Potential Genotoxicity of Sodium Benzoate and Potassium Benzoate as Food Preservatives in Health and Various Applications. Int. J. Innov. Sci. Res. 2024, 74, 212–2182024. [Google Scholar]
- Dwivedi, S.; Prajapati, P.; Vyas, N.; Malviya, S.; Kharia, A. A Review on Food Preservation: Methods, Harmful Effects and Better Alternatives. Asian J. Pharm. Pharmacol. 2017, 3, 193–199. [Google Scholar]
- Novais, C.; Molina, A.K.; Abreu, R.M.V.; Santo-Buelga, C.; Ferreira, I.C.F.R.; Pereira, C.; Barros, L. Natural Food Colorants and Preservatives: A Review, a Demand, and a Challenge. J. Agric. Food Chem. 2022, 70, 2789–2805. [Google Scholar] [CrossRef]
- He, W.-S.; Zhao, L.; Sui, J.; Li, X.; Huang, S.; Ding, H.; Zhu, H.; Chen, Z.-Y. Enzymatic Synthesis of a Novel Antioxidant Octacosanol Lipoate and Its Antioxidant Potency in Sunflower Oil. J. Agric. Food Chem. 2024, 72, 21781–21793. [Google Scholar] [CrossRef]
- Al-Maqtari, Q.A.; Rehman, A.; Mahdi, A.A.; Al-Ansi, W.; Wei, M.; Yanyu, Z.; Phyo, H.M.; Galeboe, O.; Yao, W. Application of Essential Oils as Preservatives in Food Systems: Challenges and Future Prospectives—A Review. Phytochem. Rev. 2022, 21, 1209–1246. [Google Scholar] [CrossRef]
- Islam, F.; Saeed, F.; Imran, A.; Shehzadi, U.; Ali, R.; Nosheen, F.; Chauhan, A.; Asghar, A.; Ojukwu, M. Bio-Preservatives and Essential Oils as an Alternative to Chemical Preservatives in the Baking Industry: A Concurrent Review. J. Food Sci. Technol. 2024, 61, 609–620. [Google Scholar] [CrossRef]
- Zhang, J.; Zhang, J.; Huang, X.; Shi, J.; Muhammad, A.; Zhai, X.; Xiao, J.; Li, Z.; Povey, M.; Zou, X. Study on Cinnamon Essential Oil Release Performance Based on pH-Triggered Dynamic Mechanism of Active Packaging for Meat Preservation. Food Chem. 2023, 400, 134030. [Google Scholar] [CrossRef]
- He, W.-S.; Wang, Q.; Zhao, L.; Li, J.; Li, J.; Wei, N.; Chen, G. Nutritional Composition, Health-Promoting Effects, Bioavailability, and Encapsulation of Tree Peony Seed Oil: A Review. Food Funct. 2023, 14, 10265–10285. [Google Scholar] [CrossRef]
- Perumal, A.B.; Huang, L.; Nambiar, R.B.; He, Y.; Li, X.; Sellamuthu, P.S. Application of Essential Oils in Packaging Films for the Preservation of Fruits and Vegetables: A Review. Food Chem. 2022, 375, 131810. [Google Scholar] [CrossRef]
- Wylie, M.R.; Merrell, D.S. The Antimicrobial Potential of the Neem Tree Azadirachta indica. Front. Pharmacol. 2022, 13, 891535. [Google Scholar] [CrossRef]
- Kumar, S.; Singh, N.; Devi, L.S.; Kumar, S.; Kamle, M.; Kumar, P.; Mukherjee, A. Neem Oil and Its Nanoemulsion in Sustainable Food Preservation and Packaging: Current Status and Future Prospects. J. Agric. Food Res. 2022, 7, 100254. [Google Scholar] [CrossRef]
- Wasim, A.; Bushra, H.; Rakhi, R.; Ashish, V. Comprehensive Review of the Neem Plant’s Attributes and Applications. Int. J. Res. Dev. Technol. 2023, 1, 1–14. [Google Scholar]
- Hai, Y.; Zhou, D.; Lam, Y.L.N.; Li, X.; Chen, G.; Bi, J.; Lou, X.; Chen, L.; Yang, H. Nanoemulsified Clove Essential Oils-Based Edible Coating Controls Pseudomonas Spp.-Causing Spoilage of Tilapia (Oreochromis niloticus) Fillets: Working Mechanism and Bacteria Metabolic Responses. Food Res. Int. 2022, 159, 111594. [Google Scholar] [CrossRef] [PubMed]
- Hala, A.; Neven, M.; Omara, E. Assessment the Impact of Green Tea and Rosemary Nanoemulsion on the Shelf Life of Fish Fillets. Anim. Health Res. J. 2019, 7, 68–80. [Google Scholar]
- Bai, J.; Li, J.; Chen, Z.; Bai, X.; Yang, Z.; Wang, Z.; Yang, Y. Antibacterial Activity and Mechanism of Clove Essential Oil against Foodborne Pathogens. LWT 2023, 173, 114249. [Google Scholar] [CrossRef]
- Singh, I.R.; Pulikkal, A.K. Nano Emulsions Stabilized by Natural Emulsifiers: A Comprehensive Review on Feasibility, Stability and Bio-Applicability. J. Drug Deliv. Sci. Technol. 2023, 92, 105303. [Google Scholar] [CrossRef]
- Jiang, H.; Lin, H.; Lin, J.; Adade, S.Y.-S.S.; Chen, Q.; Xue, Z.; Chan, C. Non-Destructive Detection of Multi-Component Heavy Metals in Corn Oil Using Nano-Modified Colorimetric Sensor Combined with near-Infrared Spectroscopy. Food Control 2022, 133, 108640. [Google Scholar] [CrossRef]
- Majeed, H.; Liu, F.; Hategekimana, J.; Sharif, H.R.; Qi, J.; Ali, B.; Bian, Y.-Y.; Ma, J.; Yokoyama, W.; Zhong, F. Bactericidal Action Mechanism of Negatively Charged Food Grade Clove Oil Nanoemulsions. Food Chem. 2016, 197, 75–83. [Google Scholar] [CrossRef]
- Majeed, U.; Majeed, H.; Liu, X.; Shafi, A.; Liu, T.; Ye, J.; Meng, Q.; Luo, Y. Succinylated Starch Emulsified Eugenol and Carvacrol Nanoemulsions Improved Digestive Stability, Bio-Accessibility and Salmonella typhimurium Inhibition. Int. J. Biol. Macromol. 2024, 259, 129230. [Google Scholar] [CrossRef]
- Majeed, H.; Antoniou, J.; Shoemaker, C.F.; Fang, Z. Action Mechanism of Small and Large Molecule Surfactant-Based Clove Oil Nanoemulsions against Food-Borne Pathogens and Real-Time Detection of Their Subpopulations. Arch. Microbiol. 2015, 197, 35–45. [Google Scholar] [CrossRef]
- Jabbar, M.; Baboo, I.; Majeed, H.; Farooq, Z.; Palangi, V.; Lackner, M. Preparation and Characterization of Cumin Essential Oil Nanoemulsion (CEONE) as an Antibacterial Agent and Growth Promoter in Broilers: A Study on Efficacy, Safety, and Health Impact. Animals 2024, 14, 2860. [Google Scholar] [CrossRef] [PubMed]
- Shehabeldine, A.M.; Doghish, A.S.; El-Dakroury, W.A.; Hassanin, M.M.; Al-Askar, A.A.; AbdElgawad, H.; Hashem, A.H. Antimicrobial, Antibiofilm, and Anticancer Activities of Syzygium aromaticum Essential Oil Nanoemulsion. Molecules 2023, 28, 5812. [Google Scholar] [CrossRef] [PubMed]
- Alzohairy, M.A. Therapeutics Role of Azadirachta Indica (Neem) and Their Active Constituents in Diseases Prevention and Treatment. Evid. Based Complement. Altern. Med. 2016, 2016, 7382506. [Google Scholar] [CrossRef] [PubMed]
- He, Q.; Zhang, L.; Song, L.; Zhang, X.; Liu, D.; Hu, Y.; Guo, M. Inactivation of Staphylococcus aureus Using Ultrasound in Combination with Thyme Essential Oil Nanoemulsions and Its Synergistic Mechanism. LWT 2021, 147, 111574. [Google Scholar] [CrossRef]
- Khairy, N.; Karmi, M.; Maky, M.A. Proximate Composition Analysis of Beef Sausage. Aswan Univ. J. Environ. Stud. 2021, 2, 155–161. [Google Scholar]
- Nikolaeva, T.N.; Lapshin, P.V.; Zagoskina, N.V. Method for Determining the Total Content of Phenolic Compounds in Plant Extracts with Folin–Denis Reagent and Folin–Ciocalteu Reagent: Modification and Comparison. Russ. J. Bioorg. Chem. 2022, 48, 1519–1525. [Google Scholar] [CrossRef]
- Ji, X.; Cheng, Y.; Tian, J.; Zhang, S.; Jing, Y.; Shi, M. Structural Characterization of Polysaccharide from Jujube (Ziziphus jujuba Mill.) Fruit. Chem. Biol. Technol. Agric. 2021, 8, 54. [Google Scholar] [CrossRef]
- Kusumah, N.A.F.; Widjiati, W.; Puspitasari, Y.; Tyasningsih, W.; Wardhana, D.; Permatasari, D.A.; Luqman, E.M. Comparison of Total Number of Bacteria in Raw Milk Friesian Holstein Cow Based on Milking Techniques Using Total Plate Count (TPC) Test. Int. J. Sci. Adv. 2023, 4, 1–7. [Google Scholar] [CrossRef]
- Zhai, X.; Wang, X.; Zhang, J.; Yang, Z.; Sun, Y.; Li, Z.; Huang, X.; Holmes, M.; Gong, Y.; Povey, M. Extruded Low Density Polyethylene-Curcumin Film: A Hydrophobic Ammonia Sensor for Intelligent Food Packaging. Food Packag. Shelf Life 2020, 26, 100595. [Google Scholar] [CrossRef]
- Saavedra, A.R.; Rios-Mera, J.D.; Imán, A.; Vásquez, J.; Saldana, E.; Siche, R.; Tello, F. A Sequential Approach to Reduce Sodium Chloride in Freshwater Fish Burgers Considering Chemical, Texture, and Consumer Sensory Responses. LWT 2022, 167, 113854. [Google Scholar] [CrossRef]
- Safaya, M.; Rotliwala, Y. Neem Oil Based Nano-Emulsion Formulation by Low Energy Phase Inversion Composition Method: Characterization and Antimicrobial Activity. Mater. Today Proc. 2022, 57, 1793–1797. [Google Scholar] [CrossRef]
- Rashid, A.; Qayum, A.; Liang, Q.; Kang, L.; Raza, H.; Chi, Z.; Chi, R.; Ren, X.; Ma, H. Preparation and Characterization of Ultrasound-Assisted Essential Oil-Loaded Nanoemulsions Stimulated Pullulan-Based Bioactive Film for Strawberry Fruit Preservation. Food Chem. 2023, 422, 136254. [Google Scholar] [CrossRef] [PubMed]
- Jordán, M.J.; Lax, V.; Rota, M.C.; Lorán, S.; Sotomayor, J.A. Effect of Bioclimatic Area on the Essential Oil Composition and Antibacterial Activity of Rosmarinus officinalis L. Food Control. 2013, 30, 463–468. [Google Scholar] [CrossRef]
- Ekhtelat, M.; Khalili Borujeni, F.; Siahpoosh, A.; Ameri, A. Chemical Composition and Antibacterial Effects of Some Essential Oils Individually and in Combination with Sodium Benzoate against Methicillin-Resistant Staphylococcus aureus and Yersinia enterocolitica. In Proceedings of the Veterinary Research Forum; Faculty of Veterinary Medicine, Urmia University: Urmia, Iran, 2020; Volume 11, p. 333. [Google Scholar]
- Katiyar, R.; Khare, E.; Kaistha, S.D. Concentration Dependent Effect of Azadirachta Indica (Neem) Seed Oil and Neem Bark Extract on Planktonic and Established Biofilm Growth of Pseudomonas aeruginosa and Staphylococcus aureus. J. Pure Appl. Microbiol. 2023, 17, 1669–1678. [Google Scholar] [CrossRef]
- Ali, H.A.; Hussin, Z.S.; Taaban, S.K.; Hamad, M.T.; Jasem, A.A.-R.D. Study the effect of oil extracts of moringa, rosemary and neem plants on some pathogenic bacteria. Plant Cell Biotechnol. Mol. Biol. 2021, 22, 56–63. [Google Scholar]
- Garcia, C.R.; Malik, M.H.; Biswas, S.; Tam, V.H.; Rumbaugh, K.P.; Li, W.; Liu, X. Nanoemulsion Delivery Systems for Enhanced Efficacy of Antimicrobials and Essential Oils. Biomater. Sci. 2022, 10, 633–653. [Google Scholar] [CrossRef]
- Chuesiang, P.; Sanguandeekul, R.; Siripatrawan, U. Enhancing Effect of Nanoemulsion on Antimicrobial Activity of Cinnamon Essential Oil against Foodborne Pathogens in Refrigerated Asian Seabass (Lates calcarifer) Fillets. Food Control 2021, 122, 107782. [Google Scholar] [CrossRef]
- Rolfe, C.; Daryaei, H. Intrinsic and Extrinsic Factors Affecting Microbial Growth in Food Systems. In Food Safety Engineering; Demirci, A., Feng, H., Krishnamurthy, K., Eds.; Food Engineering Series; Springer International Publishing: Cham, Switzerland, 2020; pp. 3–24. ISBN 978-3-030-42659-0. [Google Scholar]
- Pinto, L.A.D.M.; Razente, R.A.; Benito, C.E.; Gubert, L.; Stefanello, L.R.; Simões, E.P.; Júnior, R.C.D.S.; Monteschio, J.D.O.; Fernandes, J.I.M. Clove Essential Oil (Syzygium aromaticum L.) as a Natural Preservative to Improve the Shelf-life of Chicken Patties with Different Degrees of Myopathy. Food Process. Preserv. 2022, 46, e17037. [Google Scholar] [CrossRef]
- Hassanpour, M.; Partovi, R.; Shahavi, M. Shelf Life Extension of Oncorhynchus aguabonita Fillets Based on Trachyspermum copticum Essential Oil Nanoemulsion Coating during Storage at 4° C. Ank. Üniversitesi Vet. Fakültesi Derg. 2024, 71, 171–182. [Google Scholar] [CrossRef]
- Khan, Z.; Yasmeen, R.; Shafique, H.; Shahbaz, S. Antioxidant Activity of Rosemary Oil and Olive Oil and Its Impact on the Shelf Life of Fish Fillets. BioScientific Rev. 2024, 6, 122–132. [Google Scholar] [CrossRef]
- Das, J.K.; Chatterjee, N.; Nanda, P.K.; Das, A.; Nath, S.; Pal, S.; Dhar, P.; Bandyopadhyay, S.; Verma, A.K.; Sen, A.; et al. Encapsulation and Delivery of Clove Essential Oil Using Nanoemulsions: Impact on the Physicochemical, Microbial, and Sensory Properties of Chicken Meatballs. Food Biophys. 2024, 19, 701–716. [Google Scholar] [CrossRef]
- Shokri, S.; Parastouei, K.; Taghdir, M.; Abbaszadeh, S. Application an Edible Active Coating Based on Chitosan-Ferulago Angulata Essential Oil Nanoemulsion to Shelf Life Extension of Rainbow Trout Fillets Stored at 4 C. Int. J. Biol. Macromol. 2020, 153, 846–854. [Google Scholar] [CrossRef] [PubMed]
- Mehraie, A.; Khanzadi, S.; Hashemi, M.; Azizzadeh, M. New Coating Containing Chitosan and Hyssopus Officinalis Essential Oil (Emulsion and Nanoemulsion) to Protect Shrimp (Litopenaeus vannamei) against Chemical, Microbial and Sensory Changes. Food Chem. X 2023, 19, 100801. [Google Scholar] [CrossRef] [PubMed]
- Ameur, A.; Bensid, A.; Ozogul, F.; Ucar, Y.; Durmus, M.; Kulawik, P.; Boudjenah-Haroun, S. Application of Oil-in-water Nanoemulsions Based on Grape and Cinnamon Essential Oils for Shelf-life Extension of Chilled Flathead Mullet Fillets. J. Sci. Food Agric. 2022, 102, 105–112. [Google Scholar] [CrossRef]
- Aboutorab, M.; Ahari, H.; Allahyaribeik, S.; Yousefi, S.; Motalebi, A. Nano-emulsion of Saffron Essential Oil by Spontaneous Emulsification and Ultrasonic Homogenization Extend the Shelf Life of Shrimp (Crocus Sativus L.). J. Food Process. Preserv. 2021, 45, e15224. [Google Scholar] [CrossRef]

| Factor 1 | Factor 2 | Factor 3 | Response 1 | Response 2 | Response 3 | |
|---|---|---|---|---|---|---|
| Run | A: TW80 | B: Neem Oil | C: Sonication Interval | Size | PDI | Zeta Potential |
| (g) | (ml) | (min) | (nm) | (1) | (mV) | |
| 1 | 2 | 15 | 15 | 204.1 ± 0.01 | 0.21 ± 0.04 | 14.3 ± 0.07 |
| 2 | 3 | 10 | 20 | 166 ± 0.15 | 0.13 ± 0.01 | 17.5 ± 0.01 |
| 3 | 2.5 | 10 | 15 | 160.2 ± 0.04 | 0.11 ± 0.02 | 12.3 ± 0.05 |
| 4 | 3 | 10 | 10 | 220 ± 0.18 | 0.21 ± 0.05 | 14.2 ± 0.09 |
| 5 | 2 | 10 | 20 | 183.2 ± 0.09 | 0.18 ± 0.07 | 16.4 ± 0.1 |
| 6 | 2 | 10 | 10 | 201.2 ± 0.03 | 0.2 ± 0.04 | 18.2 ± 0.09 |
| 7 | 3 | 5 | 15 | 164.2 ± 0.1 | 0.13 ± 0.02 | 16.9 ± 0.11 |
| 8 | 2.5 | 5 | 20 | 167.3 ± 0.01 | 0.12 ± 0.03 | 17.3 ± 0.04 |
| 9 | 2.5 | 10 | 15 | 163.1 ± 0.03 | 0.11 ± 0.07 | 12.1 ± 0.01 |
| 10 | 3 | 15 | 15 | 162.3 ± 0.08 | 0.1 ± 0.05 | 17.8 ± 0.06 |
| 11 | 2 | 5 | 15 | 169.3 ± 0.01 | 0.12 ± 0.03 | 17.4 ± 0.05 |
| 12 | 2.5 | 15 | 20 | 163.2 ± 0.04 | 0.11 ± 0.01 | 17.8 ± 0.06 |
| 13 | 2.5 | 15 | 10 | 187.2 ± 0.11 | 0.19 ± 0.11 | 16 ± 0.02 |
| 14 | 2.5 | 5 | 10 | 194.3 ± 0.07 | 0.21 ± 0.05 | 15.9 ± 0.07 |
| Compound Name | CAS No. | Retention Time (min) | Peak Area (au) |
|---|---|---|---|
| Nimbiol | 561-95-5 | 22.69 | 115,540 |
| 6 deacetyl nimbin | 18609-16-0 | 24.29 | 100,704 |
| 6-deacetyl nimbinene | 26.91 | 114,381 | |
| 9,12,15-Octadecatrienoic acid (alpha-linolenic acid) | 463-40-1 | 27.13 | 113,306 |
| Azadirachtin | 11141-17-6 | 27.46 | 116,666 |
| Nimbandiol | 78916-53-7 | 4.33 | 1319 |
| Antibacterial Component | Minimum Inhibitory Concentration (MIC) |
|---|---|
| 3% v/v NO NE and 0.1% w/v PM | 210 ppm |
| 1% v/v NO NE | 50 ppm |
| 3% v/v NO NE | 150 ppm |
| 3% PM | 180 ppm |
| 0.1% PM | 60 ppm |
| Groups | pH (0 Day) | pH (30 Day) | Protein % (0 Day) | Protein % (30 Day) | Ash % (0 Day) | Ash % (30 Day) | Moisture % (0 Day) | Moisture % (30 Day) | Carbohydrate % (0 Day) | Carbohydrate % (30 Day) |
|---|---|---|---|---|---|---|---|---|---|---|
| 3% v/v NO NE | 6.80 ± 0.43 | 6.35 ± 0.49 | 40 ± 0.8 | 37 ± 6 | 0.25 ± 0.34 | 1.1 ± 0.25 | 8.35 ± 0.48 | 8.32 ± 0.42 | 1.20 ± 0.04 | 1.15 ± 0.07 |
| 3% v/v NO NE + 0.1% w/v PM | 6.80 ± 0.43 | 6.65 ± 0.42 | 40 ± 0.8 | 38 ± 7 | 0.25 ± 0.34 | 1.06 ± 0.20 | 8.35 ± 0.48 | 8.23 ± 0.32 | 1.20 ± 0.04 | 1.19 ± 0.07 |
| 0.1% w/v PM | 6.80 ± 0.43 | 6.35 ± 0.35 | 40 ± 0.8 | 35 ± 6 | 0.25 ± 0.34 | 1.13 ± 0.32 | 8.35 ± 0.48 | 8.20 ± 0.26 | 1.20 ± 0.04 | 1.15 ± 0.08 |
| Control | 6.80 ± 0.43 | 5.50 ± 0.38 | 40 ± 0.8 | 31 ± 6 | 0.25 ± 0.34 | 1.31 ± 0.42 | 8.35 ± 0.48 | 8.12 ± 0.08 | 1.20 ± 0.04 | 1.05 ± 0.08 |
Disclaimer/Publisher’s Note: The statements, opinions and data contained in all publications are solely those of the individual author(s) and contributor(s) and not of MDPI and/or the editor(s). MDPI and/or the editor(s) disclaim responsibility for any injury to people or property resulting from any ideas, methods, instructions or products referred to in the content. |
© 2025 by the authors. Licensee MDPI, Basel, Switzerland. This article is an open access article distributed under the terms and conditions of the Creative Commons Attribution (CC BY) license (https://creativecommons.org/licenses/by/4.0/).
Share and Cite
Kazam, J.; Iqbal, K.J.; Shafi, A.; Majeed, U.; Lackner, M. Neem Oil (Azadirachta indica L.) Response Surface Methodology (RSM)-Optimized Nanoemulsions for Sensory Quality Preservation of Oreochromis niloticus Fillets. Biology 2025, 14, 400. https://doi.org/10.3390/biology14040400
Kazam J, Iqbal KJ, Shafi A, Majeed U, Lackner M. Neem Oil (Azadirachta indica L.) Response Surface Methodology (RSM)-Optimized Nanoemulsions for Sensory Quality Preservation of Oreochromis niloticus Fillets. Biology. 2025; 14(4):400. https://doi.org/10.3390/biology14040400
Chicago/Turabian StyleKazam, Jamal, Khalid Javed Iqbal, Afshan Shafi, Usman Majeed, and Maximilian Lackner. 2025. "Neem Oil (Azadirachta indica L.) Response Surface Methodology (RSM)-Optimized Nanoemulsions for Sensory Quality Preservation of Oreochromis niloticus Fillets" Biology 14, no. 4: 400. https://doi.org/10.3390/biology14040400
APA StyleKazam, J., Iqbal, K. J., Shafi, A., Majeed, U., & Lackner, M. (2025). Neem Oil (Azadirachta indica L.) Response Surface Methodology (RSM)-Optimized Nanoemulsions for Sensory Quality Preservation of Oreochromis niloticus Fillets. Biology, 14(4), 400. https://doi.org/10.3390/biology14040400







